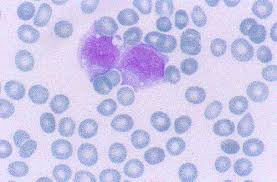

Acute lymphocytic leukemia is a form of cancer of the blood or bone marrow characterized by a rapid increase in the number of immature white blood cells. The large number of these cells renders the marrow unable to produce healthy red blood cells.
Acute lymphocytic leukemia is a form of cancer of the blood or bone marrow characterized by a rapid increase in the number of immature white blood cells. The large number of these cells renders the marrow unable to produce healthy red blood cells.
Acute lymphocytic leukemia requires immediate treatment, otherwise it metastasizes to other vital organs of the body. The acute form is found mainly in children. The disease also affects adults, especially those over 65 years old. The survival rate is 85% in children and 50% in adults.
What causes acute lymphocytic leukemia?
Chromosomal abnormalities, DNA mutations are to blame for acute lymphocytic leukemia. Mutations can occur spontaneously or as a result of exposure to radiation or carcinogens. In adults the cause is placed in natural or artificial ionizing radiation. Tobacco use is also associated with a small increase in the risk of developing acute myeloid leukemia in adults. Studies have linked exposure to petrochemicals and hair dyes to the development of leukemia, while cases of mother-to-fetus transmission have been reported.
Also, some viruses such as retrovirus (T-lymphotropic) cause adult T-cell leukemia. The disease is characterized by heredity. People with Down syndrome are more likely to develop acute leukemia. Finally, there is limited evidence that high levels of magnetic fields can cause child leukemia.
Symptoms of acute lymphocytic leukemia
Symptoms leading to the suspicion of malignancy are damage to the bone marrow which in turn leads to easy bruising, excessive bleeding, weak immune system (frequent infections, mouth sores, pneumonia), anemia, lethargy, pain to the bones and joints.
Some patients experience symptoms of night sweats, chills, fever, loss of appetite.
Diagnosis of acute lymphocytic leukemia
The diagnosis of acute lymphocytic leukemia is made exclusively through medical examinations and is based on measurements of blood cell types, myelogram and hematogram. If there is a serious suspicion of developing leukemia the doctor may use X-rays, magnetic resonance imaging or ultrasound. Mutation in the SPRED1 gene has been associated with a predisposition to child leukemia. Mutations in the SPRED 1 gene can be diagnosed by genetic testing.
Treatment of acute lymphocytic leukemia
In general, acute lymphocytic leukemia is treated with medication combined with chemotherapy. In some cases radiotherapy will be necessary and in others a bone marrow transplant. In child leukemia, chemotherapy starts with steroids, vinca alkaloids and asparaginase. After the first bone marrow recovery, stabilization chemotherapy with high-dose methotrexate follows.
Maintenance treatments can last up to 3 years in order to prevent recurrence of the disease. The precaution, which is recommended to prevent the metastasis of cancer to the brain and nervous system, includes among the measures head radiation and drugs for the spine.
Transplantation of allogeneic stem cells will sometimes be necessary.
Prevention against acute lymphocytic leukemia
The prognosis is that about 80% of children who are exposed to acute lymphocytic leukemia will overcome it, while only 1/3 of adults will be cured (without taking into account any complications).
The appropriate specialty
The right doctor for acute lymphocytic anemia is the cytologist and the hematologist.
Source: doctoranytime.gr
